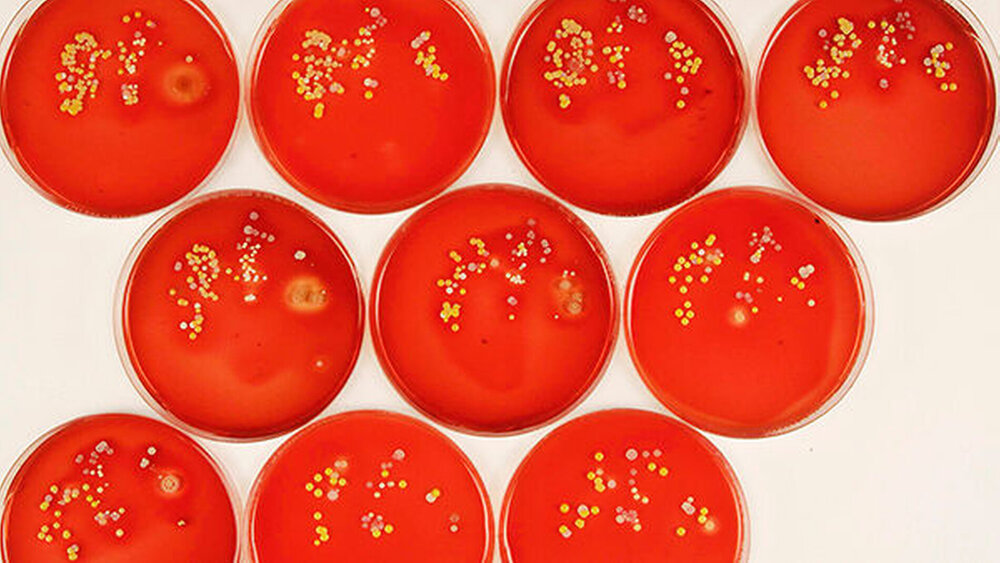
Abbildung 1: Aufeinander folgende Kontaktkulturen der nicht desinfizierten Fingerspitzen von Zeige-, Mittel- und Ringfinger der gleichen Hand. |

Zahnärztliche Händehygiene
Hände gelten als die bedeutendsten Keimüberträger in der Medizin. Sie sind ständig mit der physiologischen (residenten) Hautflora des einzelnen Mitarbeiters kontaminiert. Diese Mikroorganismen werden ohne Händedesinfektion bei jedem Kontakt auf Haut oder Schleimhaut übertragen. Bei Einsatz von Kontaktkulturen wird jeweils nur ein geringer Anteil der vorhandenen Mikroorganismen durch eine Kultur detektiert. (Abbildung 1).
Zusätzlich sind Hände (trotz des Tragens von Schutzhandschuhen) vorübergehend auch mit den Mikroorganismen der Umgebung, vor allem aber der Mundflora des Patienten sowie in dessen Blut persistierenden Viren kontaminiert (transiente Hautflora). Viren wurden in zahlreichen Studien an den Händen medizinischen Personals nachgewiesen. Eine derartige Kontamination der Hände kann durch Defekte an den Schutzhandschuhen sowie durch eine ungenügende Technik beim Ausziehen der Handschuhe hervorgerufen werden. Im akuten virämischen Stadium eines HBV-Carriers können pro Milliliter Blut etwa 5 x 108 infektiöse Einheiten enthalten sein. Das HCV-Virus ist im Blut eines infizierten Patienten immerhin noch in Konzentrationen von 104bis 107infektiösen Einheiten pro Milliliter nachweisbar. Bei diesen hohen Konzentrationen genügen kleinste Blutmengen, um Infektionen zu übertragen.
Es ist in der Humanmedizin durch zahlreiche Studien bewiesen, dass eine hygienische Händedesinfektion die Übertragung potenziell pathogener Erreger auf den Patienten und auf die Mitarbeiter verhindern kann und damit die Entstehung von Infektionen minimiert. Mit hoher Wahrscheinlichkeit kann angenommen werden, dass der Händedesinfektion in der Zahnmedizin eine ebenso große Wertigkeit bei der Infektionsverhütung wie in anderen medizinischen Fachdisziplinen zukommt. Deshalb wird die Händehygiene durch das Robert Koch-Institut auch in dessen Empfehlung zur Hygiene in der Zahnmedizin in die Evidence-Kategorie IA (Basis der nachdrücklichen Empfehlung sind gut konzipierte experimentelle oder epidemiologische Studien) eingeordnet.
Die Weltgesundheitsorganisation hat in ihrer weltweiten Kampagne „Clean care is safer care“ die Verbreitung von effektiven Maßnahmen zur Händehygiene als eines von fünf vorrangigen Zielen zur Erhöhung der Patientensicherheit genannt. Bis heute haben sich weltweit über 100 Länder schriftlich zur Umsetzung verpflichtet.
In Deutschland wird seit dem 1. Januar 2008 die „Aktion saubere Hände“ unter der Schirmherrschaft des Bundesgesundheitsministeriums durchgeführt (Abbildung 2). Ziel ist es, die Händedesinfektion als entscheidenden hygienischen Qualitätsparameter fest in den klinischen Alltag zu integrieren (Tabelle 1).
Gründe für das Tragen von Schutzhandschuhen
Das Tragen von Schutzhandschuhen gehört zu den wichtigen zahnärztlichen Distanzierungsmaßnahmen. Schutzhandschuhe sind bei der zahnärztlichen Behandlung sinnvoll, um eine Verschmutzung der Hände mit Speichel und Blut zu minimieren. Nach dem Ablegen der Schutzhandschuhe müssen die Hände desinfiziert werden, weil nicht auszuschließen ist, dass selbst fabrikneue, unbenutzte Schutzhandschuhe Perforationen aufweisen oder dass die kontaminierte Außenseite der Handschuhe beim Ablegen mit den Händen in Kontakt kommen kann. Untersuchungen konnten belegen, dass nach der Behandlung von Patienten mit bestimmten Erregern bei einem Drittel der Mitarbeiter nicht nur die Schutzhandschuhe, sondern auch die Hände der behandelnden Person nach Ablegen der Schutzhandschuhe kontaminiert waren. Daher sollten die Handschuhe zwischen der Behandlung verschiedener Patienten grundsätzlich gewechselt werden. Bei nicht zu umgehender Unterbrechung der aseptischen Arbeitsweise am gleichen Patienten können die Handschuhe mit Händedesinfektionsmittel desinfiziert und bei der Behandlung weiter getragen werden. Voraussetzung ist die Stabilität der Schutzhandschuhe gegenüber dem verwendeten Händedesinfektionsmittel.
Das alte Dogma mit Wasser und Seife
Händewaschen ist heute nicht mehr automatisch Teil der hygienischen Händedesinfektion bei einem Patientenwechsel im Sinne des langjährigen Dogmas „Erst desinfizieren, dann waschen“. Unter der Voraussetzung des Tragens von Schutzhandschuhen sollte das Waschen der Hände zwischen den Behandlungen nur noch eine Ausnahme sein. Das seltenere Händewaschen minimiert Risiken für irritative Hautveränderungen und Handekzeme durch den Verlust von Fetten sowie von wasserbindenden Faktoren der Haut.
Die Indikationen zum Händewaschen sind daher deutlich seltener als im Allgemeinen angenommen wird (Tabelle 3). In allen anderen Situationen, in denen in der Zahnarztpraxis Händehygiene erforderlich ist, sollte wegen der besseren Wirksamkeit und Hautverträglichkeit eine hygienische Händedesinfektion durchgeführt werden. Für die Händereinigung sind fließendes warmes Wasser, Flüssigseife und Handtücher zum Einmalgebrauch (Papier, Textil) notwendig. Auf den Einsatz antimikrobieller Seifen kann verzichtet werden, denn die Händewaschung soll ja nur schonend reinigen.
Wirksamere hygienische Händedesinfektion
Die Indikationen zur hygienischen Händedesinfektion in der Zahnarztpraxis sind im Hygieneplan anzugeben und in der täglichen Routine umzusetzen (Tabelle 4).
Zur hygienischen Händedesinfektion sind wegen der guten Hautverträglichkeit und der schnellen Wirksamkeit (30 Sekunden) alkoholbasierte Präparate ohne Alternative.
Eine umfassende (auch hydrophile, unbehüllte Viren einschließende) Viruzidie von Händedesinfektionsmitteln ist in der Zahnmedizin routinemäßig nicht erforderlich. Für eine gute Benetzungsqualität sind eine ausreichende Menge Desinfektionsmittel (mindestens 3 ml) sowie eine gute Einreibetechnik erforderlich. Im Hinblick auf die Technik der Händedesinfektion konnte nachgewiesen werden, dass eine eigenverantwortliche Applikationstechnik die besten Ergebnisse zeigte („Die Hände sind an jeder Stelle gründlich zu benetzen, gleich wie und in welcher Reihenfolge!“). Die allgemein bekannten und bisher gemäß DIN EN 1500 empfohlenen sechs Einreibeschritte sind zu Ausbildungs- und Trainingszwecken weiterhin gut geeignet. Vor allem die in Abbildung 3 dargestellten Benetzungstechniken werden häufig ungenügend ausgeführt.
Bei Tätigkeiten, die eine hygienische Händedesinfektion erfordern, dürfen an Händen und Unterarmen keine Schmuckstücke, Uhren und Ringe getragen werden. Das ist eine übereinstimmende Forderung des Robert Koch-Instituts und der Berufsgenossenschaften. Denn unter Fingerringen (auch Eheringen) ist die Koloniezahl transienter Bakterien erhöht und die Händedesinfektion schlechter wirksam. Das Verbot gilt auch für künstliche Fingernägel aller Art, da die bei Ringen genannten Fehlerquellen auch für künstliche Fingernägel zutreffen. Das ist durch wissenschaftliche Untersuchungen gut belegt.
Hautpflege ist wichtig
Hautkrankheiten stehen an der Spitze der den Zahnarzt und die Fachangestellte betreffenden Berufskrankheiten in Deutschland. Sie werden jedoch nur selten durch Händedesinfektionsmittel hervorgerufen. Im Gegensatz zum Händewaschen wird die Haut durch Händedesinfektionsmittel wegen des Zusatzes von rückfettenden und hautpflegenden Substanzen wesentlich geringer beeinträchtigt und die Hautfeuchtigkeit weniger reduziert als durch das Waschen mit Seife. Außerdem verdunstet der überwiegende Anteil des Händedesinfektionsmittels und lässt damit die vorher gelösten Hautfette auf der Haut zurück. Obwohl Allergien gegenüber Inhaltsstoffen aus Händedesinfektionsmitteln selten sind, ist es empfehlenswert, Händedesinfektionsmittel ohne Zusatz von Farbstoffen und Parfüm zu verwenden. Notwendig sind ebenfalls Hautpflege und Hautschutz für alle Mitarbeiter der Praxis. Eine richtig praktizierte Hautpflege kann Hautschäden verhindern beziehungsweise minimieren. Eine intakte Haut verbessert die Wirksamkeit der Händedesinfektionsmittel und dient damit auch dem Patientenschutz. Hautschutzpräparate sollten vor Arbeitsbeginn und nach jeder Pause aufgetragen werden. Nach der Arbeit sollten Pflegecremes helfen, die Regeneration der Haut zu beschleunigen. In der Zahnarztpraxis ist dazu ein Hautschutzplan zu erarbeiten, der über verfügbare Produkte und deren Anwendung informiert. Auch das ist eine Forderung der Berufsgenossenschaften.
Optimierungsmethoden für die Händehygiene
Methoden zur Optimierung der Händehygiene bei medizinischem Personal sind in den vergangenen fünf Jahren durch die Aktion „Saubere Hände“ bekannt und erfolgreich eingesetzt worden. Noch 2008 ließen Ergebnisse einer Online-Befragung durch das Institut der Deutschen Zahnärzte (IDZ) und andere zur zahnärztlichen Händehygiene ein Optimierungspotenzial erkennen.
(Damals gaben 88 Prozent der Befragten an, die Handschuhe zwischen den Patienten immer oder fast immer zu wechseln.) Entscheidend für die Verbesserung auch der zahnärztlichen Händehygiene ist das Wissen über die Bedeutung der Händehygiene zum Schutz der Patienten und des Personals der Praxis vor Infektionen. Nur wer die Notwendigkeit erkannt hat, wird im täglichen Alltag die entsprechende Compliance entwickeln. Hinzu kommen die richtigen Indikationen und die richtige Durchführung der Händedesinfektion.
Alle genannten Punkte lassen sich in drei Fragen komprimieren:
1. Warum ist eine Händedesinfektion für den Infektionsschutz wesentlich?
2. Wann ist eine Händedesinfektion erforderlich?
3. Wie sind die Hände zu desinfizieren?
Das Vorbild des Zahnarztes ist wesentlich für die Bereitschaft der Mitarbeiter zur Händehygiene. Vor allem der Praxisinhaber muss seiner so wichtigen Vorbildfunktion auch tatsächlich nachkommen. Es wird für alle anderen Mitarbeiter sehr viel schwerer, die Händedesinfektion zu unterlassen, wenn die Vorgesetzten ein gutes Vorbild sind.
Entsprechend sind bei unterlassener oder fehlerhafter Händedesinfektion die Mitarbeiter auf diese Tatsache hinzuweisen. Fehlende Konsequenz ist die Basis für ungenügende Compliance mit den Regeln. Das erklärt unter anderem, warum im Rahmen der Qualitätssicherung Qualitätsparameter zur Händedesinfektion diskutiert werden.
Für den stationären Bereich ist der Verbrauch an Händedesinfektionsmitteln in Millilitern pro Patientenbehandlung ein tendenziell wichtiger Qualitätsparameter der Hygiene. Als Faustregel kann gelten: Wenn sich Zahnarzt und Assistenz vor und nach der Behandlung eines Patienten die Hände desinfizieren, können 12 ml Händedesinfektionsmittel schnell verbraucht worden sein. Von Bedeutung ist auch die Ausstattung der Behandlungsplätze und Aufbereitungsräume mit Spendern für Händedesinfektionsmittel. Ein solcher Spender sollte in unmittelbarer Nähe zur Dentaleinheit verfügbar sein.
Zusammenfassung
Die Hände des zahnärztlichen Personals sind das wichtigste Übertragungsvehikel von Krankheitserregern in der Zahnmedizin. Die Händehygiene ist daher eine der wesentlichen Maßnahmen zur Verhütung von Infektionen in der Zahnarztpraxis. Das Tragen von Schutzhandschuhen bei zu erwartendem Schleimhautkontakt minimiert die Kontamination der Hände.
Zur Dekontamination der Hände ist aufgrund der im Vergleich zum Händewaschen besseren Wirksamkeit und Hautverträglichkeit eine hygienische Händedesinfektion indiziert. Waschen mit Wasser und Flüssigseife ist grundsätzlich nur bei sichtbar mit Speichel oder Blut des Patienten verschmutzten Händen erforderlich. Alkoholische Händedesinfektionsmittel sind empfehlenswert.
Die Compliance der Händedesinfektion kann durch die Vermittlung der wichtigsten Situationen, in denen eine Händedesinfektion einen infektionspräventiven Nutzen hat, verbessert werden. Die optimale Technik der Händedesinfektion ist durch regelmäßiges Training zu optimieren. Der Verbrauch an Händedesinfektionsmitteln pro Patient und die Anzahl patientennaher Spender in der Zahnarztpraxis sind mögliche wesentliche Qualitätsindikatoren der Hygiene.
Prof. Dr. Lutz Jatzwauk
Bereich Krankenhaushygiene und Umweltschutz Universitätsklinikum Carl Gustav Carus
Fetscherstr. 74
01307 Dresden
MR Dr. Klaus Neumann
Tzschimmerstr. 17
01309 Dresden
Prof. Dr. Bernd Reitemeier
UniversitätsZahnMedizin
Universitätsklinikum Carl Gustav Carus
Fetscherstr. 74
01307 Dresden
E-Learning
Eine Wissensvermittlung ist durch den Besuch oder die Organisation von Fortbildungsveranstaltungen möglich. Eine in der Medizin relativ neue Methode der Wissensvermittlung stellt das electronic learning (E-Learning) dar.
Unter E-Learning werden alle Formen von Lernen verstanden, bei denen digitale Medien (Online-Lernen, Telelernen, computergestütztes Lernen) für die Präsentation und Distribution von Lernmaterialien und/oder zur Unterstützung zwischenmenschlicher Kommunikation zum Einsatz kommen. Ein solches E-Learning-Programm steht nun auch für die Wissensvermittlung der zahnärztlichen Händehygiene zur Verfügung.
Der Lernende kann sich so unabhängig von fest terminierten Fortbildungsveranstaltungen mit dem Thema beschäftigen. Die Fragen des Lernprogramms bleiben dabei unverändert. Bei wiederholter Anwendung werden die im Multiple-Choice-Verfahren vorgegebenen Antworten jedoch bei jedem neuen Zugriff auf das Lernprogramm in neuer Reihenfolge präsentiert. Dies zwingt den Lernenden, sich den Sinn und nicht die Position der richtigen Antwort einzuprägen. Es sind sowohl Fragen zu den Indikationen als auch zur praktischen Durchführung der Händedesinfektion enthalten.
Unabhängig davon, ob nach ein bis drei möglichen Versuchen die richtige Antwort gefunden wurde, können Leitlinien beziehungsweise Publikationen zum Thema geöffnet werden, so dass eine spezifische Wissensvertiefung möglich ist. Abschließend wird dem Lernenden das Testergebnis präsentiert.
Desinfektionstraining
Die Benetzungstechnik der Hände mit dem Desinfektionsmittel muss trainiert werden. Ein didaktisch überzeugendes und effizientes Training bietet der Einsatz von fluoreszierenden Testlösungen zum Einreiben in die Hände in Kombination mit speziellem UV-Licht. Gefahren der Keimübertragung von Hand zu Hand (Ringe, Handschuhperforation) lassen sich ebenso zeigen wie Benetzungslücken bei der Händedesinfektion (Abbildung 4).